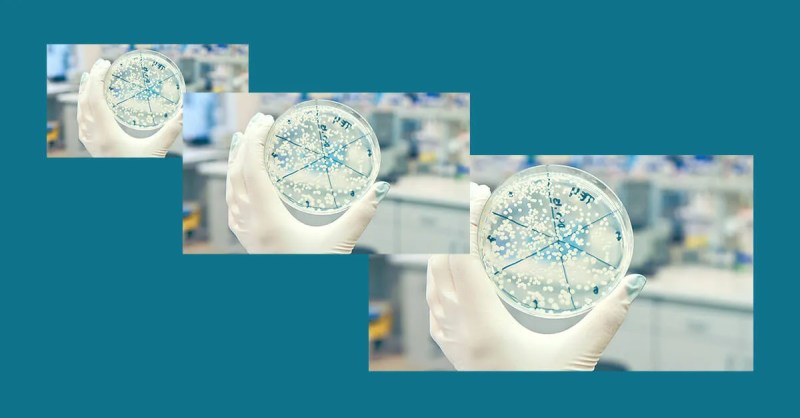

Officials warn against traveling to Northern California, Florida, New York, Washington State
[Editor’s Note: This article has been updated by a more recent story found HERE.]
A third person has tested positive for the coronavirus in Wisconsin, with local government and health officials confirming Tuesday the individual lives in Dane County and cautioning against travel in certain parts of the U.S.
The person was exposed while traveling in the United States and is currently isolated at home. Dane County health officials are working to determine the people who have been in contact with the patient to isolate or quarantine people and test those who are exhibiting symptoms.
“We are working with our local health departments to make sure everyone who has been in contact with our confirmed cases is notified. We continue to urge state residents to take precautions to avoid illness,” said State Health Officer Jeanne Ayers. “As guidance is evolving, it’s important for people to monitor the DHS and Centers for Disease Control and Prevention (CDC) websites for the latest information and guidance on COVID-19.”
The state’s second case was reported late Monday, an individual in Pierce County who tested positive and also only traveled within the U.S.
Ayers confirmed the latest individual in Dane County and the individual in Pierce County both tested positive after traveling to areas known as community spread areas within the United States.
These are areas where the virus is spreading despite the fact the individuals who test positive for the virus have had no contact with another infected person and have not traveled to an area where others have tested positive.
Northern California, Washington State, Florida and New York are areas of community spread. Ayers cautioned Wisconsin residents with upcoming plans for spring break to reconsider.
“We recommend not traveling to community-spread areas,” Ayers told reporters on a conference call Tuesday.
She said those with such pre-existing conditions should be “very judicious in any non-essential travel.” This includes people of all ages with kidneys issues, heart disease and respiratory issues such as COPD or a history of lung cancer.
People who have traveled in the past 14 days to northern California, Washington State, Florida and New York or any international location where the virus has been identified are being asked to self-quarantine themselves and monitor for a fever and cough for 14 days.
If symptoms, like fever, cough, or difficulty breathing are present, they should contact their local health department and health care provider for possible testing. Individuals are being asked to call the health care facility prior to their arrival in an effort to keep the virus from spreading.
Dr. Ryan Westergaard, the chief medical officer with the Bureau of Communicable Disease, said people need to maintain awareness of the areas of the country that report community spread.
“It is a very dynamic situation,” he said.
Ayers said one reason the virus has spread slowly in Wisconsin is because of those who have self-quarantined themselves after traveling.
“We so much appreciate all the people who have up-ended their lives and self-quarantined,” Ayers said. “We do not underestimate the impact that has had on their lives. It has helped us tremendously slow the introduction of the virus into the state of Wisconsin.”
The first individual to contract the disease arrived in Madison in early February from a trip to China. That person has fully recovered from the virus, according to state health officials.
This story will be updated following a briefing from the Wisconsin Department of Health Services.